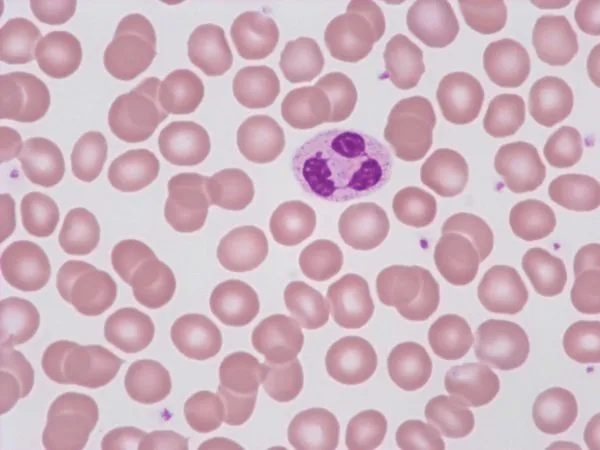
mikroskopowy obraz komórek krwi

Ten artykuł stanowi kompleksowy przewodnik po specjalizacji hematologa, wyjaśniając, kim jest ten lekarz, jakimi chorobami się zajmuje i kiedy warto się do niego zgłosić. Znajdziesz tu również praktyczne wskazówki dotyczące przygotowania do wizyty oraz przebiegu diagnostyki i leczenia, co pomoże zrozumieć i oswoić się z tematem chorób krwi.
Hematolog specjalista od zdrowia krwi i układu krwiotwórczego
- Hematolog to lekarz zajmujący się diagnostyką i leczeniem chorób krwi, szpiku kostnego, węzłów chłonnych, śledziony i wątroby.
- Wizyta u hematologa jest wskazana przy nieprawidłowych wynikach morfologii krwi lub objawach takich jak przewlekłe zmęczenie, bladość, nadmierne siniaczenie, powiększone węzły chłonne czy niewyjaśniona utrata masy ciała.
- Specjalista ten diagnozuje i leczy szeroki zakres schorzeń, w tym niedokrwistości, zaburzenia krzepnięcia (np. hemofilia, trombofilia) oraz nowotwory krwi (białaczki, chłoniaki, szpiczaki).
- Diagnostyka obejmuje podstawowe badania krwi, a także zaawansowane testy, takie jak biopsja szpiku kostnego czy badania genetyczne.
- W ramach NFZ do hematologa wymagane jest skierowanie od lekarza POZ lub innego specjalisty.
Kim jest hematolog i czym się zajmuje
Hematolog to lekarz specjalizujący się w diagnostyce i leczeniu chorób krwi oraz całego układu krwiotwórczego. Ten układ jest niezwykle złożony i obejmuje nie tylko krew krążącą w żyłach, ale także szpik kostny, węzły chłonne, śledzionę oraz wątrobę. Moim zdaniem, to właśnie ta kompleksowość sprawia, że hematologia jest tak fascynującą, ale i wymagającą dziedziną medycyny.
Hematologia ma charakter interdyscyplinarny, co oznacza, że łączy się z wieloma innymi specjalizacjami, takimi jak onkologia (w przypadku nowotworów krwi), transplantologia (przeszczepy szpiku), immunologia (choroby autoimmunologiczne wpływające na krew) czy genetyka (wrodzone choroby krwi). Lekarz podstawowej opieki zdrowotnej (POZ) najczęściej kieruje pacjentów do hematologa, gdy zauważy nieprawidłowości w podstawowym badaniu morfologii krwi lub niepokojące objawy. Zawsze podkreślam, że wczesne rozpoznanie jest kluczowe, dlatego nie należy lekceważyć sygnałów wysyłanych przez organizm.
Oto kluczowe objawy i nieprawidłowości w morfologii krwi, które powinny skłonić do wizyty u hematologa:
- Przewlekłe osłabienie i zmęczenie, które utrzymuje się pomimo odpoczynku i nie ma wyraźnej przyczyny.
- Bladość skóry i błon śluzowych, często widoczna na wewnętrznej stronie powiek czy dziąsłach.
- Nadmierna skłonność do siniaczenia, pojawianie się siniaków bez wyraźnego urazu lub po bardzo lekkim uderzeniu.
- Trudne do zatamowania krwawienia, na przykład z nosa, dziąseł, czy przedłużające się krwawienia miesiączkowe.
- Powiększone węzły chłonne (szyjne, pachowe, pachwinowe), które są twarde, niebolesne i utrzymują się przez dłuższy czas.
- Nocne poty, szczególnie obfite, niezwiązane z wysoką temperaturą otoczenia.
- Nawracające infekcje, które są częstsze i trudniejsze do wyleczenia niż zazwyczaj.
- Niewyjaśniona utrata masy ciała, bez zmiany diety czy aktywności fizycznej.
- Nieprawidłowe wyniki morfologii krwi, takie jak obniżony poziom hemoglobiny, zbyt niska lub zbyt wysoka liczba białych krwinek, płytek krwi, czy nieprawidłowy rozmaz.
Choroby diagnozowane i leczone przez hematologa
Jako hematolog, zajmuję się niezwykle szerokim spektrum chorób, zarówno tych o charakterze nienowotworowym, jak i nowotworowym. Zrozumienie, jakie schorzenia wchodzą w zakres mojej specjalizacji, jest kluczowe dla pacjentów, którzy szukają odpowiedniej pomocy. Najczęściej spotykam się z niedokrwistościami, czyli anemiami. To stany, w których organizm ma zbyt mało zdrowych czerwonych krwinek lub hemoglobiny. Do najczęstszych typów należą niedokrwistość z niedoboru żelaza, niedokrwistość z niedoboru witaminy B12 lub kwasu foliowego, a także bardziej złożone anemie hemolityczne (gdzie czerwone krwinki są niszczone) oraz anemie aplastyczne (gdzie szpik kostny nie wytwarza wystarczającej liczby komórek krwi).
Inną dużą grupą chorób są zaburzenia krzepnięcia krwi. Mogą one objawiać się jako skazy krwotoczne, czyli nadmierna tendencja do krwawień, takie jak hemofilia (wrodzony niedobór czynników krzepnięcia), małopłytkowość (zbyt mało płytek krwi) czy choroba von Willebranda (zaburzenie funkcji płytek i czynników krzepnięcia). Z drugiej strony, zajmuję się również stanami nadkrzepliwości, zwanymi trombofiliami, które zwiększają ryzyko powstawania zakrzepów, co może prowadzić do poważnych komplikacji, takich jak zakrzepica żył głębokich czy zatorowość płucna.
Niestety, część mojej pracy to również diagnostyka i leczenie nowotworów krwi i układu chłonnego. Są to schorzenia, które budzą największy lęk, ale dzięki postępowi medycyny wiele z nich jest dziś uleczalnych lub możliwych do kontrolowania. Do tej grupy zaliczamy białaczki (ostre i przewlekłe), chłoniaki (zarówno ziarnicze, jak i nieziarnicze, w tym chłoniak Hodgkina), szpiczak plazmocytowy (nowotwór komórek plazmatycznych szpiku kostnego) oraz zespoły mielodysplastyczne i mieloproliferacyjne, takie jak czerwienica prawdziwa czy nadpłytkowość samoistna, które mogą z czasem przekształcić się w ostrzejsze formy nowotworów. W tych przypadkach, jak w żadnych innych, wczesna i precyzyjna diagnoza ma fundamentalne znaczenie.Pierwsza wizyta u hematologa: Jak się przygotować
Przygotowanie do pierwszej wizyty u hematologa jest niezwykle ważne i może znacząco przyspieszyć proces diagnostyczny. Przede wszystkim, proszę, aby pacjenci zabrali ze sobą kompletną dokumentację medyczną. Obejmuje to wszystkie poprzednie wyniki morfologii krwi (nawet te sprzed kilku lat, jeśli były nieprawidłowe), wyniki badań biochemicznych, a także wypisy ze szpitala czy konsultacje od innych specjalistów. Warto również przygotować listę przyjmowanych leków, w tym suplementów diety, oraz zanotować daty rozpoczęcia i zakończenia ich stosowania.
Podczas wizyty przeprowadzam szczegółowy wywiad lekarski. Zawsze pytam o aktualne objawy kiedy się pojawiły, jak są nasilone i co je łagodzi lub nasila. Ważna jest również historia chorób, zarówno pacjenta, jak i jego rodziny, ponieważ wiele chorób krwi ma podłoże genetyczne. Pytam także o styl życia, dietę, ewentualne podróże, a także o wszelkie niepokojące zmiany, które pacjent zauważył w swoim samopoczuciu. Moim celem jest zebranie jak najszerszego obrazu klinicznego.Następnie przechodzę do badania fizykalnego. Zwracam szczególną uwagę na stan skóry i błon śluzowych, szukając bladości, wybroczyn czy siniaków. Bardzo dokładnie palpuję węzły chłonne w różnych okolicach ciała (szyja, pachy, pachwiny), aby ocenić ich wielkość, konsystencję i bolesność. Badam również jamę brzuszną, aby ocenić wielkość wątroby i śledziony, ponieważ ich powiększenie może być ważnym sygnałem w chorobach hematologicznych. To kompleksowe podejście pozwala mi na wstępne ukierunkowanie diagnostyki.
Diagnostyka hematologiczna: Kluczowe badania
- Morfologia krwi z rozmazem i retikulocytami: To podstawowe badanie, które dostarcza informacji o liczbie czerwonych i białych krwinek, płytkach krwi oraz poziomie hemoglobiny. Rozmaz krwi pozwala ocenić kształt i dojrzałość komórek, a liczba retikulocytów informuje o aktywności szpiku kostnego w produkcji czerwonych krwinek. To często pierwszy krok, który wskazuje na potencjalny problem.
- Badania biochemiczne: Obejmują one ocenę poziomu żelaza, ferrytyny (białka magazynującego żelazo), witaminy B12 i kwasu foliowego. Ich niedobory są częstą przyczyną niedokrwistości. Badamy również parametry nerkowe i wątrobowe, które mogą być zaburzone w wielu chorobach krwi.
- Parametry krzepnięcia (APTT, PT/INR, fibrynogen): Te testy oceniają sprawność układu krzepnięcia krwi, co jest kluczowe w diagnostyce skaz krwotocznych lub stanów nadkrzepliwości. Pomagają zidentyfikować, czy problem leży w niedoborze lub dysfunkcji czynników krzepnięcia.
- Biopsja aspiracyjna i trepanobiopsja szpiku kostnego: To bardziej inwazyjne, ale często niezbędne badania. Biopsja aspiracyjna polega na pobraniu próbki płynnego szpiku kostnego, natomiast trepanobiopsja to pobranie fragmentu kości z rdzeniem szpikowym. Pozwalają one na szczegółową ocenę komórek szpiku, wykrycie komórek nowotworowych oraz ocenę struktury szpiku.
- Biopsja węzła chłonnego: W przypadku powiększonych węzłów chłonnych, pobranie fragmentu tkanki do badania histopatologicznego jest kluczowe dla rozpoznania chłoniaków i innych limfoproliferacyjnych chorób.
- Badania cytogenetyczne i molekularne: To zaawansowane testy, które analizują materiał genetyczny komórek krwi lub szpiku. Pozwalają wykryć specyficzne mutacje genów czy aberracje chromosomowe, które są charakterystyczne dla wielu nowotworów krwi (np. białaczek, szpiczaka) i mają kluczowe znaczenie dla wyboru odpowiedniej terapii.
- Badania obrazowe (USG jamy brzusznej, TK, PET-CT): Ultrasonografia jamy brzusznej pozwala ocenić wielkość śledziony i wątroby. Tomografia komputerowa (TK) i pozytonowa tomografia emisyjna (PET-CT) są wykorzystywane do oceny rozległości choroby nowotworowej, lokalizacji powiększonych węzłów chłonnych czy nacieków w innych narządach.
Metody leczenia chorób krwi
Leczenie chorób krwi jest bardzo zróżnicowane i zawsze dostosowywane indywidualnie do pacjenta oraz konkretnego schorzenia. Moim zadaniem jest wybranie najskuteczniejszej i najbezpieczniejszej terapii, często w oparciu o najnowsze wytyczne i badania naukowe. Oto główne metody leczenia, które stosujemy w hematologii:
- Suplementacja niedoborów: W przypadku niedokrwistości spowodowanych niedoborem żelaza, witaminy B12 czy kwasu foliowego, podstawą leczenia jest uzupełnianie tych substancji. Może to odbywać się doustnie lub, w niektórych przypadkach, dożylnie.
- Leczenie farmakologiczne: Obejmuje szeroki wachlarz leków. W przypadku nowotworów krwi stosujemy chemioterapię, która ma na celu zniszczenie komórek nowotworowych. Coraz większą rolę odgrywa immunoterapia, która wykorzystuje układ odpornościowy pacjenta do walki z chorobą, oraz terapie celowane, które działają precyzyjnie na konkretne mechanizmy molekularne w komórkach nowotworowych, minimalizując uszkodzenia zdrowych tkanek.
- Transfuzje preparatów krwiopochodnych: W sytuacjach nagłych lub w przebiegu przewlekłych chorób, gdy organizm nie produkuje wystarczającej liczby komórek krwi, konieczne mogą być transfuzje. Mogą to być transfuzje koncentratu krwinek czerwonych (w przypadku ciężkiej niedokrwistości), koncentratu płytek krwi (przy małopłytkowości) lub osocza (w zaburzeniach krzepnięcia).
- Przeszczepianie komórek krwiotwórczych (przeszczep szpiku): To jedna z najbardziej zaawansowanych i często ratujących życie metod leczenia, stosowana głównie w nowotworach krwi (np. białaczkach, chłoniakach) oraz niektórych ciężkich niedokrwistościach. Polega na podaniu pacjentowi zdrowych komórek krwiotwórczych (pobranych od dawcy lub samego pacjenta), które odbudowują prawidłowo funkcjonujący układ krwiotwórczy.
Przeczytaj również: Lekarz NFZ: 10 minut? Jak wykorzystać wizytę na 100%?
Jak umówić wizytę u hematologa
W Polsce zasady umawiania wizyty u hematologa różnią się w zależności od tego, czy korzystamy z publicznej opieki zdrowotnej w ramach Narodowego Funduszu Zdrowia (NFZ), czy decydujemy się na wizytę prywatną. W przypadku leczenia w ramach NFZ, niezbędne jest skierowanie. Może je wystawić lekarz podstawowej opieki zdrowotnej (POZ) lub inny lekarz specjalista, który uzna, że konsultacja hematologiczna jest konieczna. Bez skierowania niestety nie ma możliwości skorzystania z bezpłatnej wizyty.
Jeśli natomiast pacjent zdecyduje się na wizytę prywatną, skierowanie nie jest wymagane. W takiej sytuacji można bezpośrednio umówić się na konsultację w wybranej placówce medycznej. Ważne jest, aby pamiętać, że nawet w przypadku wizyty prywatnej, zabranie ze sobą pełnej dokumentacji medycznej i wyników wcześniejszych badań jest kluczowe dla efektywnego przebiegu konsultacji i postawienia trafnej diagnozy.